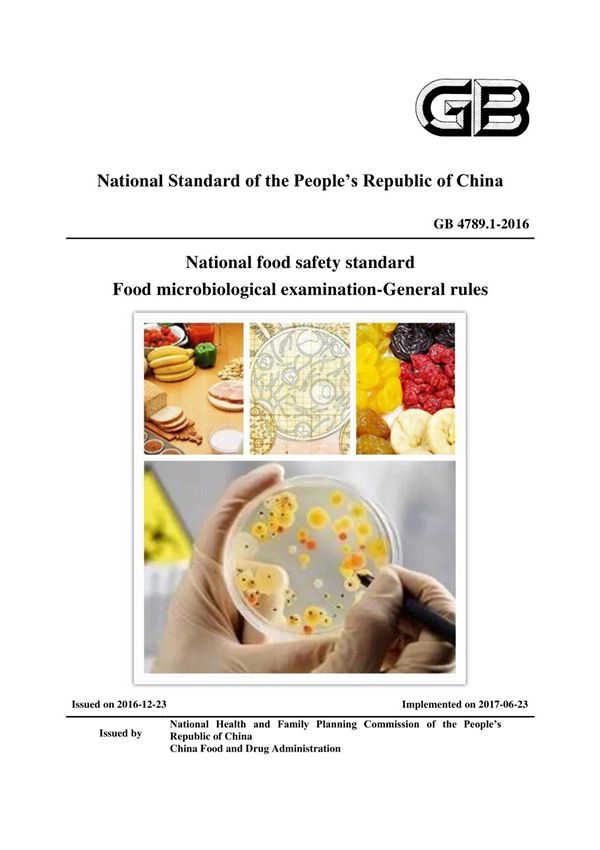
GB-4789.1-2016-食品安全国家标准-食品微生物学检验-总则-译文(EN)

TheGB4789.1-2016"NationalFoodSafetyStandard-FoodMicrobiologicalExamination-GeneralPrinciples"isakeyregulatorydocumentissuedbytheChinesegovernmenttostandardizemicrobiologicaltestingmethodsforfoodproducts.AspartofChina'sfoodsafetystandardssystem,thisstandardprovidesfundamentalguidelines,technicalrequirements,andproceduralnormsformicrobiologicalanalysisinfoodtestinglaboratories.Thestandardcoversessentialaspectssuchaslaboratoryfacilities,equipmentrequirements,samplehandlingprocedures,testingmethodologies,qualitycontrolmeasures,anddatareporting.ItservesasthefoundationforsubsequentspecificmicrobiologicaltestingstandardsintheGB4789series,ensuringconsistencyandreliabilityinfoodsafetyassessments.ComplyingwithinternationalpracticeswhileaddressingChina'sspecificregulatoryneeds,GB4789.1-2016playsacrucialroleinsafeguardingfoodqualityandprotectingconsumerhealth.ThisEnglishtranslationaimstofacilitateunderstandingandimplementationforinternationalstakeholdersengagedinfoodtrade,qualitycontrol,orregulatorycompliancewithChinesefoodsafetystandards.